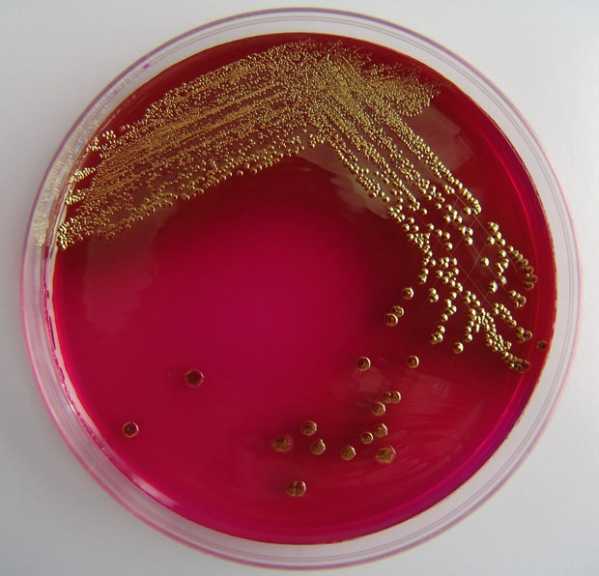

Кишечная палочка — Медицинская википедия
Кишечная палочка (лат. Escherichia coli, E. coli, по имени Теодора Эшериха) — грамотрицательная палочковидная бактерия, широко встречается в нижней части кишечника теплокровных организмов. Большинство штаммов E. coli являются безвредными, однако серотип O157:H7 может вызывать тяжёлые пищевые отравления у людей. Безвредные штаммы являются частью нормальной флоры кишечника человека и животных. Кишечная палочка приносит пользу организму хозяина, например, синтезируя витамин K, а также предотвращая развитие патогенных микроорганизмов в кишечнике.
E. coli не всегда обитают только в желудочно-кишечном тракте, способность некоторое время выживать в окружающей среде делает их важным индикатором для исследования образцов на наличие фекальных загрязнений. Бактерии легко могут быть выращены в лабораторных условиях, поэтому кишечная палочка играет важную роль в генетических исследованиях. E. coli является одним из самых изученных прокариотических микроорганизмов и одним из самых важных объектов биотехнологии и микробиологии.
E. coli была описана немецким педиатром и бактериологом Теодором Эшерихом в 1885 году. В настоящее время кишечную палочку относят к роду Escherichia, семейству Enterobacteriaceae, порядку Enterobacteriales.
Штаммы
Модель последовательного бинарного деления E. coli | ||||||||||
Штамм — это совокупность особей внутри вида, которая обладает свойствами, отличными от свойств других особей. Часто такие отличия могут быть обнаружены только на молекулярном уровне, однако, имеют эффект на физиологию бактерии или жизненный цикл. Разные штаммы E. coli часто специфичны к определённым хозяевам, что делает возможным определение источника фекального заражения в образцах. Например, если известно, какие штаммы E. coli представлены в образце воды, можно определить источник заражения, например, человек, другое млекопитающее или птица.
Новые штаммы E. coli появляются в результате мутаций и горизонтального переноса генов. Некоторые штаммы вырабатывают особенности, губительные для организмов хозяина, такие вирулентные штаммы могут вызывать диарею, что неприятно в случае взрослых и может привести к летальному исходу у детей в развивающихся странах. Более вирулентные штаммы, например, O157:H7 вызывают тяжёлые заболевания и даже приводят к смерти у пожилых людей, маленьких детей и лиц с ослабленным иммунитетом.
Биология и биохимия
E. coli — грамотрицательная бактерия, факультативный анаэроб, не образует эндоспор. Клетки палочковидные, со слегка закруглёнными концами, размером 0,4—0,8 х 1—3 мкм, объём клетки составляет около 0,6—0,7 μm³. Кишечная палочка может жить на разных субстратах. В анаэробных условиях E. coli образует в качестве продукта жизнедеятельности лактат, сукцинат, этанол, ацетат и углекислый газ. Часто при этом образуется молекулярный водород, который мешает образованию указанных выше метаболитов, поэтому
Оптимальный рост достигается культурами E. coli при температуре 37 °C, некоторые штаммы могут делиться при температурах до 49 °C. Рост может стимулироваться аэробным или анаэробным дыханием, различными парами окислителей и восстановителей, в том числе, окислением пирувата, формиата, водорода, аминокислот, а также восстановлением кислорода, нитрата, диметилсульфоксида и триметиламин N-оксида.
Штаммы, имеющие жгутики, способны передвигаться. Жгутики расположены перитрихально. На конце жгутика расположен белок FimH, который прикрепляется к молекулам сахаров на поверхности, а сам жгутик состоит из цепочки взаимосвязанных белковых сегментов, закрученных в форме тонкой длинной пружины и упруго вытягивающихся при воздействии силы.
Роль в нормальной микрофлоре
E. coli в норме заселяет кишечник новорождённого ребенка в течение 40 часов после рождения, поступая с пищей или от лиц, контактирующих с ребёнком, и сохраняются на протяжении жизни на уровне 106—108 КОЕ/г содержимого толстой кишки. В ЖКТ кишечные палочки прилипают к слизистым оболочкам и являются основными представителями факультативных анаэробов у человека. Так как кишечные палочки не имеют бактериофагов, кодирующих факторы вирулетности, они являются комменсалами. По другим данным, микроорганизмы (в том числе, E. coli), начинают заселять человеческий организм ещё в утробе матери.
Непатогенный штамм Escherichia coli Nissle 1917 известен как Mutaflor и используется в медицине в качестве пробиотика, в основном для лечения желудочно-кишечных заболеваний, в том числе, у новорождённых.
Модельный организм
E. coli часто используют в качестве модельного организма в микробиологических исследованиях. Культивируемые штаммы, например,
В 1946 году Джошуа Ледерберг и Эдуард Тейтем описали явление конъюгации бактерий, используя кишечную палочку в качестве модельного организма. E. coli остаётся одним из наиболее востребованных бактерий при изучении конъюгации и в настоящее время. E. coli была важным компонентом первых экспериментов по генетике бактериофагов, ранние исследователи, например, Сеймор Бензер, использовали E. coli и фаг T4 для изучения структуры генов. До исследований Бензера не было известно, имеет ген линейную или разветвлённую структуру.
Кишечная палочка E. coli была одним из первых организмов, чей геном был полностью секвенирован. Последовательность нуклеотидов в геноме штамма К12 E. coli была опубликована в журнале Science в 1997 году.
Долговременный эксперимент по эволюции E. coli был начат Ричардом Ленски в 1988 году и позволил непосредственно наблюдать эволюционные изменения в лабораторных условиях. В данном эксперименте одна популяция E. coli получила возможность аэробно метаболизировать цитрат. Такая способность встречается у E. coli в норме крайне редко. Неспособность к росту в аэробных условиях используют для того, чтобы отличить E. coli от других, родственных бактерий, например, Salmonella. В ходе данного эксперимента в лабораторных условиях удалось наблюдать процесс видообразования.
Биотехнология
E. coli играет важную роль в современной промышленной микробиологии и биологической инженерии. Работа Стенли Нормана Коэна и Герберта Бойера на
Кишечную палочку считают универсальным организмом для синтеза чужеродных белков. В E. coli исследователи вводят гены при помощи плазмид, что позволяет осуществлять биосинтез белков для промышленной ферментации. Также разработаны системы для синтеза в E. coli рекомбинантных белков. Одним из первых примеров использования технологии рекомбинантных ДНК является синтез аналога инсулина человека. Модифицированные E. coli используют при разработке вакцин, синтеза иммобилизованных ферментов и решения других задач. Однако, в организме E. coli невозможно получать некоторые крупные белковые комплексы, содержащие дисульфидные связи, в частности, белки, для проявления биологической активности которых требуется посттрансляционная модификация.
Патогенность
Непатогенные бактерии E. coli, в норме в больших количествах населяющие кишечник, могут, тем не менее, вызвать развитие патологии при попадании в другие органы или полости человеческого тела. Если бактерия попадает через отверстие в ЖКТ в брюшную полость, может возникнуть перитонит. Попав и размножившись во влагалище женщины, бактерия может вызвать или осложнить кольпит. Попадание бактерии в предстательную железу мужчины может быть патогенезом острого или хронического бактериального простатита. В таких случаях в лечение включается применение антибиотиков, проводимое таким образом, чтобы не подавлять нормальную микрофлору кишечника, иначе возможно развитие дисбактериоза.
E. coli очень чувствительна к таким антибиотикам, как стрептомицин или гентамицин. Однако, E. coli может быстро приобретать лекарственную устойчивость.
Желудочно-кишечные инфекции
Вирулентные штаммы E. coli в норме отсутствуют в кишечнике, и заболевание наступает при заражении алиментарным путем. Передача патогенных E. coli часто происходит фекально-оральным путём. Частые пути передачи могут быть вызваны: низкой гигиеной приготовления пищи, загрязнением продуктов навозом, поливом урожая загрязнённой водой или сточными водами, при выпасе диких свиней на пашнях, употреблением для питья воды, загрязнённой сточными водами.
Вирулентные штаммы E. coli могут вызывать гастроэнтериты, воспаления мочеполовой системы, а также менингит у новорождённых. В редких случаях вирулентные штаммы также вызывают гемолитический-уремический синдром, перитонит, мастит, сепсис и грамотрицательную пневмонию.
Низкотемпературная электронная микрофотография кластера E. coli. Увеличение в 10 000 раз. Индивидуальные бактерии представлены округлёнными цилиндрами
Некоторые штаммы E. coli, например, O157:H7, O121 и O104:h31, синтезируют потенциально смертельные токсины. Пищевые отравления, инфекционным агентом при которых являются вирулентные E. coli, обычно вызваны употреблением в пищу немытых овощей или непрожаренного мяса.
Первичными резервуарами E. coli O157:H7 является мясной и молочный скот, который может переносить бактерии бессимптомно и выделять с фекалиями.В случае заболеваний кишечника у новорождённых, при болезни Крона и при неспецифическом язвенном колите обнаруживают повышенные уровни E. coli в слизистых ЖКТ[43]. Инвазивные штаммы E. coli обнаружены в воспалённых тканях, а количество бактерий в очагах воспаления коррелирует с тяжестью воспаления в кишечнике.
Вирулентные штаммы E. coli могут вызывать гастроэнтериты, воспаления мочеполовой системы, а также менингит у новорождённых. В редких случаях вирулентные штаммы также вызывают гемолитический-уремический синдром, перитонит, мастит, сепсис и грамотрицательную пневмонию.
Низкотемпературная электронная микрофотография кластера | ||||||||||
Некоторые штаммы E. coli, например, O157:H7, O121 и O104:h31, синтезируют потенциально смертельные токсины. Пищевые отравления, инфекционным агентом при которых являются вирулентные E. coli, обычно вызваны употреблением в пищу немытых овощей или непрожаренного мяса.
Первичными резервуарами E. coli O157:H7 является мясной и молочный скот, который может переносить бактерии бессимптомно и выделять с фекалиями.
В случае заболеваний кишечника у новорождённых, при болезни Крона и при неспецифическом язвенном колите обнаруживают повышенные уровни E. coli в слизистых ЖКТ. Инвазивные штаммы E. coli обнаружены в воспалённых тканях, а количество бактерий в очагах воспаления коррелирует с тяжестью воспаления в кишечнике.
Менингит новорождённых
Один из серотипов Escherichia coli содержит антиген K1. Заселение кишечника новорождённого данным серотипом бактерий при попадании бактерий из влагалища матери может приводить к менингиту. В отсутствие IgM от матери, которые не способны проникать через гемато-плацентарный барьер, и потому, что организм распознаёт K1 как собственный антиген, данный серотип вызывает тяжёлые воспаления мозга.
Лечение фагами
Терапия бактериофагами для лечения патогенных бактерий была разработана более 80 лет назад в Советском Союзе, где использовалась для лечения диареи, вызванной E. coli. В настоящее время фаговая терапия доступна лишь в Центре фаговой терапии в Грузии и в Польше.
Бактериофаг Т4 является хорошо изученным фагом, инфицирующим E. coli.
Вакцина
Исследователи разрабатывают эффективные вакцины для снижения количества случаев заражения патогенными штаммами E. coli по всему миру.
В апреле 2009 года исследователи Мичиганского университета заявили о том, что разработали вакцину для одного из штаммов E. coli. Подана заявка на патент.
См. также
medviki.com
Кишечная палочка (escherichia coli): Коллектор Рассеянной Информации
Кишечная палочка (эшерихия коли, лат. escherichia coli; общепринятое сокращение e. coli) — вид грамотрицательных палочко-видных бактерий, входящий в состав нормальной микрофлоры желудочно-кишечного тракта человека.
Вид эшерихия коли (e coli) входит в род эшерихии (лат. escherichia), семейство энтеробактерии (лат. enterobacteriaceae), порядок энтеробактерии (лат. enterobacteriales), класс гамма-протеобактерии (лат. γ proteobacteria), тип протеобактерии (лат. proteobacteria), царство бактерии.
Существует большое число разновидностей кишечной палочки (escherichia coli), в том числе, более 100 патогенных («энтеровирулентных«) типов, объединенных в четыре класса: энтеропатогенные, энтеротоксигенные, энтероинвазивные и энтерогемморагические. Морфологические различия между патогенными и непатогенными эшерихиями отсутствуют.
Кишечные палочки. Общие сведения
Кишечные палочки (escherichia coli) устойчивы во внешней среде, длительное время сохраняются в почве, воде, фекалиях. Хорошо переносят высушивание. Кишечные палочки обладают способностью к размножению в пищевых продуктах, особенно в молоке. Быстро погибают при кипячении и воздействии дезинфицирующих средств (хлорной извести, формалина, фенола, сулемы, едкого натра и др.). Кишечные палочки более устойчивы во внешней среде по сравнению с другими энтеробактериями. Прямой солнечный свет убивает их в течение нескольких минут, температура 60°С и 1% раствор карболовой кислоты — в течение 15 минут.Часть кишечных палочек имеет жгутики и подвижны. У других кишечных палочек жгутики и способность к движению отсутствуют.
Escherichia coli в кишечнике и кале человека
Число кишечных палочек escherichia coli среди других представителей микрофлоры кишечника не превышает 1%, но они играют важнейшую роль в функционировании желудочно-кишечного тракта. Кишечные палочки e coli являются основными конкурентами условно-патогенной микрофлоры в отношении заселения ими кишечника. Кишечные палочки e coli забирают из просвета кишечника кислород, который вреден для полезных для человека бифидо- и лактобактерий. Кишечные палочки e coli вырабатывают ряд необходимых для человека витаминов: В1, В2, В3, В5, В6, В9, B12, К, участвует в обмене холестерина, билирубина, холина, желчных и жирных кислот, оказывает влияние на всасывание железа и кальция.
Escherichia coli в кишечнике человека появляются в первые дни после рождения и сохраняются на протяжении жизни на уровне 106—108 КОЕ/г содержимого толстой кишки. В фекалиях здорового человека кишечные палочки (типичные) выявляются в количестве 107—108 КОЕ/г, при этом количество лактозонегативных кишечных палочек не должно превышать 105 КОЕ/г, а гемолитические кишечные палочки должны отсутствовать.
Отклонения от указанных значений является признаком дисбактериоза:
снижение типичных кишечных палочек до 105—106 КОЕ/г, или повышение содержания типичных эшерихий до 109—1010 КОЕ/г определяется, как первая степень микробиологических нарушений
повышение концентрации гемолитических кишечных палочек до до 105—107 КОЕ/г определяется, как вторая степень микробиологических нарушений
При избыточном росте кишечных палочек детям рекомендуется прием бактериофагов (в зависимости от типа кишечной палочки): бактериофаг коли жидкий, бактериофаг колипротейный жидкий, пиобактериофаг комбинированный жидкий, пиополифаг в таблетках, пиобактериофаг поливалентный очищенный жидкий или интести-бактериофаг жидкий.
При избыточном росте кишечной палочки, как следствии дисбактериоза, кроме бактериофагов, при медикаментозной терапии применяются различные пробиотки (Бифидумбактерин, Лактобактерин, Ацилакт, Аципол и др.) и/или адекватные конкретному штамму e. coli и причине дисбактериоза антибиотики (у взрослых).
Эшерихиозы
Патогенные серотипы кишечных палочек могут быть причиной эшерихиозов — различных инфекционных заболеваний, протекающих с интоксикацией, лихорадкой, обычно с поражением желудочно-кишечного тракта, реже — мочевыводящих, желчевыводящих путей, других органов или с развитием сепсиса. Эшерихиозы чаще встречаются у детей раннего возраста. Механизм распространения эшерихиозов ЖКТ — фекально-оральный. Чаще всего заражение происходит через загрязнённую пищу или воду.
Энтеропатогенная кишечная палочка
Кишечные инфекции, вызываемые энтеропатогенными штаммами кишечных палочек, развиваются чаще всего в тонкой кишке у детей первого года жизни, в том числе у новорождённых. Заболевание сопровождается сильным поносом с водянистым стулом без примеси крови, выраженными болями в животе, рвотой. Энтеропатогенные escherichia coli являются частой причиной диарей в родильных домах.Энтеро-токсигенная кишечная палочка
Энтеротоксигенные кишечные палочки обладают способностью прикрепляться к эпителиальным клеткам слизистой оболочки тонкой кишки и продуцировать токсины, вызывающих диарею. Энтеротоксигенные кишечные палочки являются основной причиной острых диарей у детей и взрослых и наиболее частой причиной так называемой «диареей путешественников».
Энтеро-гемморагическая кишечная палочка
Энтерогеморрагические кишечные палочки являются причиной геморрагического колита, а также тяжелого заболевания — гемолитико-уремического синдрома (микроангиопатической гемолитической анемии, сочетающейся с почечной недостаточностью).
Для геморрагического колита характерно острое начало в виде сильных спастических болей в животе и водной диареи, которая вскоре становится кровавой. Лихорадка обычно отсутствует, но у некоторых температура тела может достигать 39 °С. В легких случаях геморрагического колита продолжается 7–10 дней. Приблизительно в 5% случаев геморрагический колит осложняется геморрагическим синдромом, острой почечной недостаточностью и гемолитической анемией.
Энтеро-инвазивная кишечная палочка
Энтероинвазивные кишечные палочки являются причиной заболеваний, похожих по проявлению на бактериальную дизентерию (причиной которой являются шигеллы). Энтероинвазивные кишечные палочки, так же как и шигеллы, проникают и размножаются в эпителиальных клетках кишечника. У больного отмечаются боли в животе, обильный водянистый понос с примесью крови.
Escherichia coli — возбудитель заболеваний мочеполовых органов
Инфицирование кишечными палочками (а также другими уропатогенными микробами, обитающими в кишечнике) мочеполовых органов, особенно у женщин, часто происходит непосредственно из желудочно-кишечного тракта при недостаточном соблюдении гигиены или применении специфических сексуальных практик. Кишечные палочки являются причиной около 80 % внебольничных инфекций мочевыводящих путей.
Бактериурия — наличие бактерий в моче может является признаком воспаления в мочевыводящих путях, мочевом пузыре, почках. При отсутствии каких-либо симптомов, истинная бактериурия (инфекция мочевых путей) диагностируется при наличии не менее 105 микробных тел кишечных палочек (или других энтеробактерий) в 1 мл свежевыпущенной мочи, иначе предполагается, что загрязнение мочи происходит при ее заборе. Если бактериурия не сопровождается какими-либо симптомами, тогда она называется бессимптомной. Бессимптомная бактериурия не всегда требует немедленного лечения.
При наличии симптомов или при заборе мочи катетером диагностический порог может быть значительно уменьшен. В частности, при наличии клинической симптоматики (лихорадка, озноб, тошнота, рвота, боли в поясничной области, дизурия) и выделении не менее 10 лейкоцитов в 1 мкл мочи, критерием для диагностики острого пиелонефрита является наличие не менее 104 кишечных палочек (или других патогенных энтеробактерий) в 1 мл свежевыпущенной мочи. Острый цистит диагностируется при наличии соответствующей клинической симптоматики, выделении не менее 10 лейкоцитов в 1 мкл мочи и обнаружении не менее 102 кишечных палочек (или других колиформных бактерий) в 1 мл мочи.
Escherichia coli — компонент лекарственных препаратов
Специально подобранные штаммы эшерихии коли входят в состав лекарств: Хилак форте, Бификол, Колибактерин и других.
bio-kri.blogspot.com
причины, симптомы, лечение и последствия
В кишечнике находится много разных бактерий. Одни считаются полезными, а другие – вредными. Кишечная палочка относится ко второй группе. Когда ее норма в организме превышается, то появляются проблемы со здоровьем. О причинах и лечении человека рассказано в статье.
Что это такое?
Кишечной палочкой называют бактерии, которые входят в род Escherichia семейство Enterobacteriaceae. Данные микроорганизмы имеют высокую устойчивость, они могут в течение долгих месяцев жить в воде, почве, фекалиях. Группа болезней, которые связаны с кишечной палочкой и вызываются патогенными штаммами бактерии, имеют название эшерихиозов. Из-за них появляются проблемы в пищеварении и мочеполовой системе. Бактерии способны быстро размножаться в продуктах, особенно молоке, поэтому употребление зараженных и обсемененных блюд палочкой приводит к развитию инфекционно-воспалительного недуга.
Классы
Кишечные палочки делятся на условно-патогенные и патогенные. Учеными выделено свыше сотни патогенных штаммов бактерий, которые делятся на классы. Они могут быть:
- энтероинвазивными;
- энтеротоксигенными;
- энтеропатогенными;
- энтерогеморрагическими.
Данные микроорганизмы приводят к развитию эшерихиозов – болезней инфекционного вида, которые обычно наблюдаются у детей и женщин. Бывает кишечная палочка в моче, желудке. Если не будет своевременного лечения, то вероятны осложнения.
Почему попадает в организм?
Палочка способна существовать и размножаться при температуре 37 градусов. Она питается в кишечнике минеральными компонентами и продуктами распада аминокислот. Оставаясь жизнеспособной, палочка проникает в водоемы, почву и продукты.
Род эшерихий входит в семейство энтеробактерий. Многие виды микроорганизмов являются полезными для нас. Некоторые штаммы являются патогенными – провоцируют пищевые отравления, мочеполовые инфекции. Во время сложных иммунодефицитных состояний, когда палочка распространена по организму, может появиться менингит, сепсис. Если появилась кишечная палочка, причины этого просты. Основным фактором заражения считается несоблюдение гигиены.

Есть 2 способа передачи инфекции:
- Водный. Инфекция способна проникнуть в организм из-за употребления некипяченой или некачественной воды.
- Алиментарный. Инфекция передается через зараженную пищу, что приводит к пищевому отравлению.
Оральным способом эшерихия проникает в кишечный тракт по следующим причинам:
Контактно-бытовой способ встречается нечасто. Обычно он наблюдается во время вспышки эшерихиоза в отдельном помещении. Опасным путем заражения палочкой считается передача инфекции при родах от матери к ребенку.
Как проявляется?
Каковы симптомы кишечной палочки? Они проявляются по-разному, поэтому все классы надо рассматривать отдельно. Состояние зараженного человека зависит от группы кишечной палочки и ее скорости размножения. Но в целом болезненность проявляется в виде:
- нарушения пищеварительного процесса;
- рвоты и тошноты;
- проявления метеоризма;
- слабости;
- сонливости;
- ухудшения аппетита;
- повышения температуры;
- падения давления.

Так проявляется наличие кишечной палочки у взрослых и детей. Симптомов может быть как несколько, так и только один.
Симптомы по видам бактерий
Эшерихиоз, появившийся от энтероинвазивных палочек, приводит к поражению толстого отдела кишечника. Проявляется болезнь такими симптомами:
- слабостью;
- головной болью;
- ознобом;
- высокой температурой.
Через несколько часов появляется схваткообразная боль внизу живота. Наблюдается диарея, водянистый и обильный стул. При поражении толстой кишки возникает колит. Этот вид заболевания имеет доброкачественное лечение. Температура и стул нормализуется уже через 1-3 дня.
Инфекция, вызванная энтеропатогенными палочками, у взрослых и детей от 3 лет протекает так же, как и сальмонеллез. Начало заболевания характеризуется:
- тошнотой;
- рвотой;
- болями в животе;
- повышением температуры тела.
Стул будет жидким, водянистым, обильным. Человек посещает туалет 2-6 раз в сутки. Инфекция развивается 3-6 дней, а затем наступает выздоровление.

Энтеротоксигенные кишечные палочки считаются опасным из-за того, что могут присоединяться к слизистой оболочке кишечника, что приводит к нарушению его работы. Инфекция может передаваться через грязные руки или фрукты. С ней появляется:
- водянистый понос;
- тошнота;
- приступообразная боль в животе.
К симптомам энтерогеморрагической инфекции относят:
- некроз;
- наличие кровяных сгустков в кале;
- перитонит;
- диарею.
Кишечная палочка у ребенка имеет более тяжелое течение, особенно с поражением новорожденных или детей с низкой массой тела. Поэтому важно своевременно предпринимать меры по устранению данного недуга.
Осложнения
При некоторых видах палочек вероятно появление:
- отравления;
- колибактериоза;
- кишечного дисбактериоза;
- кольпита;
- простатита;
- воспаления мочеполовой системы, цистита;
- менингита у новорожденных.
Иногда из-за воспаления вероятно появление:
- перитонита;
- пневмонии;
- сепсиса;
- мастита.

Опасна кишечная палочка во влагалище женщины, поскольку может привести к воспалению половых органов. Сначала возникает вульвовагинит или кольпит. Если своевременно не избавиться от возбудителя, то инфекция переходит к маточным трубам и к матке. Появляется эндометрит. Когда бактерии двигаются по организму, они проникают в брюшную полость, развивается перитонит. Заболевание от кишечной палочки в моче или желудке может проявляться по-разному и способно привести к множеству осложнений. А своевременное лечение позволит устранить недуг.
По причине несоблюдения правил личной гигиены и при половом акте кишечная палочка может проникнуть во влагалище. В дальнейшем это приводит к воспалению мочевых органов – циститу, пиелонефриту. Но кишечная палочка в мазке не всегда свидетельствует о наличии болезни. Присутствующие бактерии в небольшом количестве могут означать, что перед сдачей анализа не были выполнены необходимые гигиенические мероприятия. Но если при анализе мочи было выявлено не меньше 102-104 кишечных палочек при наличии признаков болезни, тогда вероятно воспаление, протекающее в почках или мочевом пузыре.
Диагностика
Это мероприятие осуществляется посредством бактериологического исследования. Часто с присутствием палочки в исследовательском материале, который считается основной частью микрофлоры кишечника, не просто выделить чистую культуру бактерии. Если в организме есть воспаление, требуется срочное лечение.
Анализ проводится по:
- каловым и рвотным массам;
- крови;
- моче;
- гною;
- мазкам и соскобам.
Как лечить?
Лечение кишечной палочки должно быть комплексным. Оно состоит из следующих пунктов:
- Антибиотики. Такая терапия является основой лечения кишечной палочки. Препараты назначаются после установления чувствительности к ним микроорганизмов. Обычно требуются антибиотики группы цефалоспоринов: «Цефелим», «Цефалексин», «Левофлоксацин». Средства необходимо принимать курсами по 5-10 дней.
- Бактериофаги. Данные лекарства уничтожают бактерии мягко и безопасно, по сравнению с антибиотиками, но они не всегда оказываются эффективными. Из бактериофагов выделяются «Секстафаг», «Интести-бактериофаг».
- Обезболивающие средства. При сильных болях в животе прописываются обезболивающие лекарства, например «Но-шпа», «Брал», «Спазмалин», «Нурофен». Но их не стоит принимать в течение продолжительного времени.
- Пробиотики. К самым популярным относят «Линекс», «Бифидумбактерин». Препараты восстанавливают нормальный баланс патогенных и полезных микроорганизмов в кишечнике.
Что требуется при эшерихиозе?
Лечение эшерихиоза выполняется в стационарных условиях:
- При легких формах инфекции не нужны антибактериальные средства.
- Если форма инфекции среднетяжелая, то необходимы антибиотики группы фторхинолонов, такие как «Норфлоксацин».
- Тяжелые формы устраняются цефалоспоринами, фторхинолонами с аминогликозидами.
Прежде чем принимать какие-либо лекарственные препараты, необходимо проконсультироваться со специалистом. Также нужно читать инструкцию, где указаны правила лечения. Соблюдение рекомендаций позволит за короткое время восстановить самочувствие.
Принципы лечения
Помимо приема антибиотиков, больному необходимо соблюдать и другие правила лечения. При поносе или рвоте требуется употреблять регидратационные растворы. С ними восполняется потерянная жидкость и соль. После каждого опорожнения кишечника и рвоты надо выпивать 300-600 мл регидратационного раствора. Чтобы его приготовить, применяется аптечный порошок «Трисоль», «Регидрон» или «Глюкосолан».

Чтобы обеспечить качественное лечение заболеваний, вызванных кишечной палочкой, желательно принимать энтеросорбенты:
- «Полисорб».
- «Энтеросгель».
- «Полифепан».
- «Смекта».
- «Фильтрум»
Важно придерживаться диетического меню. Устранить кишечную палочку получится с соблюдением специального режима питания. В рационе должны быть каши, сваренные на воде, слизистые супы, отварные овощи, нежирное мясо и рыба, которые готовят на пару. Нельзя употреблять копчености, жирные, жареные блюда, консервы, молоко, свежие фрукты, пряности.
У грудничков
Часто появляется кишечная палочка у грудничков. Основным путем передачи считается фекально-оральный. Гемолизирующая палочка проникает с молоком матери или во время родов. Размножается кишечная палочка по разным причинам, но обычно это связано со снижением иммунной защиты ребенка. Переносчиками могут быть руки детей, так как они часто тянут их в рот.
Обращаться к врачу надо при появлении первых признаков проблем с кишечником. Самолечение может быть вредным. Только специалист может определить инфекцию и выбрать лечение. Грудничка могут лечить дома или в стационаре. Часто назначаются специальные средства, к примеру «Смекта». Это мягкий сорбент, устраняющий инфекцию. Токсичные компоненты быстро и естественно устраняются из организма ребенка.

Грудничкам не следует давать антибиотики. Многие препараты способны избавить от поноса, но не могут устранить инфекцию. А «Смекта» создает защитную оболочку, которая способна предохранить от бактерий и микробов. Порошок растворяют в воде. Его надо давать в бутылочке, растворяя 1 пакетик. Лечение длится 3 дня. За этот период симптомы обычно исчезают. Но если это не помогло, то нужно другое лечение.
Если ребенку прописывают другие лекарства, то «Смекту» надо давать лишь спустя 2 часа. Если врач рекомендует стационарное лечение, то лучше выбрать его, поскольку инфекция у грудного ребенка является опасным явлением. Из-за поноса и рвоты ослабевает детский организм.
В больнице за ребенком будет постоянный надзор. Там собирают анализы для выявления возбудителя. Так как результаты предоставляются не сразу, а помощь нужна срочная, ребенка могут поместить под капельницу с глюкозой. Это требуется для восстановления уровня жидкости и понижения температуры. Еще в больницах грудничкам предоставляются противорвотные и жаропонижающие средства. Спустя сутки будут готовы анализы, которые позволят определить дальнейшее лечение.
Профилактика
Уничтожение кишечной палочки происходит во время приготовления пищи, выпечки, пастеризации. Данное правило действует при условии, что температура составляет не меньше 70 градусов, а длительность – от 2 минут. По сравнению с другими бактериями, кишечная палочка более устойчива к холоду, кислой среде, сушке и повышенной концентрации соли.

Профилактика для защиты от болезней, появившихся из-за кишечных палочек, заключается в следующем:
- Важно соблюдать личную гигиену. Для этого надо тщательно мыть руки и лицо после улицы и многолюдных мест. Важно внимательно относиться к интимной гигиене.
- Необходимо мыть сырые продукты и доводить до необходимого состояния молоко и мясо.
- Пить надо лишь качественную воду.
- В больнице следует использовать одежду одноразового применения.
- Нужно контролировать гигиену и состояние здоровья домашних животных.
- Следует регулярно убирать жилое помещение с помощью качественных, но не агрессивных средств.
- Важно соблюдать осторожность при приемах пищи в заведениях общественного питания и в период отпуска.
Итог
Таким образом, кишечная палочка является опасной проблемой, причем как у взрослых, так и у детей. Важно выявить причину и своевременно приступить к лечению. Это позволит не допустить осложнений.
fb.ru
Кишечные заболевания. Кишечная палочка, клинические проявления.
01 Июл 2012
автор adminрубрики Медицина Теги: кишечная палочка, кишечные заболевания
Кишечные заболевания- это группа соматических и инфекционных заболеваний человека. Эшерихиозы- это инфекционные кишечные заболевания.
Кишечные заболевания- это группа соматических и инфекционных заболеваний человека. Эшерихиозы- это инфекционные кишечные заболевания.
Возбудитель эшерихиозов- кишечная палочка, представитель основной аэробной( живёт только в присутствии кислорода) микрофлоры кишечника. Этот микроорганизм при определённых условиях способен вызвать обширную группу заболеваний человека. Содержание кишечной палочки рассматривают как санитарный показатель при анализе воды и пищевых продуктов.
Эпидемиология
Кишечная палочка или Escherichia coli названа по фамилии немецкого врача Теодора Эшериха, который в 1885 году выделил эти бактерии из кишечника здорового ребёнка. Это прямые палочковидные бактерии, которые в мазках располагаются одиночно или парами. В настоящее время кишечную палочку считают наиболее распространённым возбудителем инфекций среди прочих бактерий условно-патогенной флоры кишечника. Патогенность E.coli связана с выделением особых веществ колицинов, которые вызывают гибель родственных бактерий.
Кишечная палочка чувствительна к фагам и антибиотикам, Входит в состав микрофлоры толстой кишки теплотворных животных, пресмыкающихся и рыб. E.blattae обитает в кишечнике тараканов.
E.coli чувствительна к обычным дезинфектантам. При кипячении погибает в течение 10-20 минут. Температурный оптимум для её роста 37*С.
Кишечные проявления
Кишечная палочка вызывает :
— кишечные инфекции;
— поражения мочевыводящих путей;
— бактериемии;
— менингиты;
— респираторные инфекции.
Кишечные палочки, вызывающие коли-инфекции делятся на 5 типов:
— энтеротоксигенные (ЕТЕС),
— энтероирвазивные (ЕIEC),
— энтеропатогенные (ЕPEC),
— энтерогеморрагические (ЕNEC),
— энтероадгезивные (EPEC), эта группа наименее изучена, впервые выделены в 1985 году.
Энтеротоксигеннные кишечные палочки. Патогенность этих бактерий связана выработкой термолабильного токсина по действию напоминающего токсин холерного вибриона.
ETEC вызывают поражения 4 типов:
1 в слаборазвитых странах- основные возбудители гастроэнтеритов у детей младшего возраста;
2 в развитых странах- этиологический фактор «диареи путешественников»;
3 гастроэнтериты в странах с жарким климатом;
4 пищевые токсикоинфекции.
Энтероинвазивные кишечные палочки (О143,О144) проникают в клетки эпителия кишечника, что сопровождается клиническими симптомами, напоминающими дизентерию: боли в животе, профузный водянистый понос с примесью крови. В испражнениях большое количество лейкоцитов, что говорит о воспалительном процессе в кишечнике. Заболеваемость регистрируется в США, Израиле, России и т.д.
Энтеропатогенные кишечные палочки только прикрепляются к клеткам эпителия кишечника и повреждают ворсинки на их поверхности, что сопровождается болями в животе, рвотой, водянистым стулом без примеси крови. Заболевание протекает тяжело и длительно до 2-х недель и более. Это основные возбудители диарей у детей.
Энтерогеморрагические кишечные палочки- небольшая группа бактерий, вызывающая диарею с примесью крови (геморрагический колит) при отсутствии лейкоцитов в испражнениях и лихорадки у больного.
Эти бактерии вызывают также гемолитико-уремический синдром (гемолитическая анемия с почечной недостаточностью).
Возбудители- О157 и О26. последний значительно реже.
Механизм передачи коли-инфекций фекально-оральный.
Человек заражается при употреблении:
-инфицированной пищи, в т.ч. молока,
— воды (ETEC, EIEC, EPEC),
-при контакте с животными.
В стационарах и закрытых коллективах, в т.ч. дошкольных учреждениях, реализуется контактный путь передачи инфекции.
Сезонность:
— в странах с умеренным климатом рост заболеваемости приходится на тёплый период года;
— в тропиках, где доминируют инфекции, вызванные ETEC и EPEC, пик заболеваемости приходится на сезон дождей.
Установить природный резервуар патогенных кишечных палочек невозможно, так как эшерихии обитают в кишечнике большого числа животных.
Зарегистрирован факт циркуляции кишечной палочки О157 у крупного рогатого скота. При употреблении в пищу термически плохо обработанной говядины, регистрировались случаи геморрагических колитов у людей.
Чтобы получать новости с моего сайта заполните форму ниже:
также на эту тему, Вы можете почитать:
Назад ЛЕЧЕНИЕ КРАСОТОЙ. Вперед Кишечные заболевания. Кишечная палочка, диагностика, профилактика.
Написать комментарий
karapuzzik.com
симптомы и лечение у детей и взрослых Отравление.ру

Содержание статьи
Заражение кишечной палочкой – опасное заболевание, которое требует незамедлительного лечения. В противном случае бактерии распространяются по всему организму и проводят к поражению внутренних органов.
Что представляет собой кишечная палочка
 Кишечная палочка – это разновидность бактерий, которые имеют палочковидную форму. Они принадлежат к группе анаэробных факультативных бактерий. Это означает, что существовать и размножаться они могут исключительно в условиях отсутствия кислорода.
Кишечная палочка – это разновидность бактерий, которые имеют палочковидную форму. Они принадлежат к группе анаэробных факультативных бактерий. Это означает, что существовать и размножаться они могут исключительно в условиях отсутствия кислорода.
Кишечная палочка имеет несколько разновидностей. Часть из них относится к разряду непатогенных. Они присутствуют в теле каждого из нас. Роль кишечной палочки в организме человека – стимулировать синтез витамина К и подавлять развитие вредной микрофлоры. Патогенные формы бактерии способны приводить к развитию серьезных заболеваний.
Кишечная палочка существует и размножается при условии температуры окружающей среды на уровне 37 градусов. Она питается в кишечнике минеральными веществами и продуктами распада аминокислот. Сохраняет свою жизнеспособность, попадая в водоемы, почву и продукты. От того, где живет бактерия, будет зависеть способ инфицирования.
Разновидности кишечной палочки
На сегодняшний день выявлено несколько патогенных штаммов этой бактерии. Они способны провоцировать различные заболевания. Выделяют следующие виды кишечных палочек:
- Энтеропатогенные. Чаще всего встречается эта кишечная палочка у ребенка. После попадания на слизистую поверхность кишечника она запускает процесс ее разрушения. Бактерии препятствую нормальному всасыванию питательных веществ в кровь человека. Поражается в первую очередь тонкая кишка.
- Энтеротоксигенная. Бактерии, прикрепившиеся ворсинками к эпителию желудочно-кишечного тракта, выделяют токсины. Они становятся благоприятной средой для развития кишечной палочки.
- Гемолитическая. Эта разновидность бактерии считается самой опасной. Она становится причиной угнетения функций кишечника и желудка. В некоторых случаях ее жизнедеятельность приводит к мышечному параличу внутренних органов.
- Энетроинвазивная. Развитие такой инфекции сопровождается появлением сильных болевых ощущений, кровавой диареи. Если вовремя не принять меры, наступит серьезная стадия обезвоживания организма.
- Энтерогеморрогическая. Эти бактерии за короткое время проникают в клетки тела и вызывают их отмирание. Деятельность такой кишечной палочки приводит к развитию гемморагического колита и поражению почек.
От разновидности бактерии зависит проявление инфекции. Поэтому определить возбудителя часто можно по характерной симптоматике.
Какие болезни провоцирует кишечная палочка
Бактерия кишечная палочка может вызывать несколько различных заболеваний. Заражение такими микроорганизмами принято называть эшерихиозом. Проявляется проблема по-разному, в зависимости от локализации очага. Выделяют следующие заболевания, которые провоцируются бактерией:
- В результате активности энтеропатогенной бактерии появляется нарушение работы пищеварительной системы, которое в первую очередь выражается энтероколитом. Такое явление чаще встречается у детей, посещающих детский сад. Инфицирование может произойти и в роддоме или больнице.
- Энтеротоксигенные бактерии вызывают симптомы, аналогичные холере. Заражение происходит путем употребления инфицированной воды и продуктов питания. В некоторых случаях происходит развитие менингита, сепсиса, отита и других осложнений.
- Энтероинвазивные бактерии приводят к появлению инфекции, аналогичной дизентерии. При серьезной степени поражения инфекция поражает мочеполовую систему. Диагностируется цистит у женщин, пиелонефрит, заболевания предстательной железы у мужчин и другие проблемы.
- Энтерогеморрагическая кишечная палочка опасна развитием тяжелых инфекционных заболеваний кишечника у детей. Причем последствия такой болезни могут быть весьма тяжелыми: почечная недостаточность, анемия, падение концентрации тромбоцитов в крови.
- Опасно попадание любых бактерий во влагалище женщины. Это приводит к воспалению половых органов. Вначале появляется вульвовагинит или кольпит. Если вовремя не устранить возбудителя, инфекция поднимается к маточным трубам и матке. Развивается эндометрит. При дальнейшем движении бактерий вверх по организму они попадают в брюшную полость, наблюдается перитонит. Болезнь, вызванная кишечной палочкой, проявляется по-разному и может иметь массу осложнений на органы и системы тела. Поэтому возбудителя необходимо выявить как можно раньше и незамедлительно приступить к лечению.
Каким путем можно заразиться
Немаловажный вопрос, как передается кишечная палочка. Только зная пути заражения, можно предотвратить инфицирование. Выделяют следующие способы, как можно заразиться бактерией:
- Контактный. Кишечная палочка передается от человека к человеку. Возбудитель может жить в ротовой полости, на коже, прятаться в царапинах. Поэтому подцепить инфекцию можно даже при простом рукопожатии. Кроме того, бактерии могут некоторое время жить и на бытовых предметах, которыми пользовался зараженный человек.
- Алиментараный. Возбудитель попадает во внешнюю среду посредством дефекации. Он переносится насекомыми на любые предметы. Оттуда и попадает в организм человека, который не соблюдает всех норм гигиены.
- Воздушно-капельный. Заразиться можно даже при разговоре с больным человеком. Слюна, испаряясь, смешивается с воздухом. Радиус такого поражения составляет около трех метров.
Основным источником, откуда берется бактерия, становится человек. Вспышки инфекционных заболеваний характерны для мест большого скопления людей, например, образовательные учреждения, больницы, детские сады.
Контактируя с предметами, зараженный человек инфицирует их. Например, для здорового ребенка опасны игры с теми же игрушками, чтение тех же книг и использование той же мебели, что и больные дети.
Еще одним местом, где обитает кишечная палочка, становится вода. Для того чтобы заболеть, иногда достаточно просто попить воды из крана. Чаще всего такое случается, если пить воду, находясь на отдыхе за границей.
Даже при условии наличия на водопроводе мощной системы фильтрации, пить воду из него не стоит. Некоторые разновидности бактерий могут выживать и в таких условиях.
Причины инфицирования могут крыться и в употреблении некачественных продуктов питания. Особенно опасной становится молочнокислая среда, в которой микроорганизмы могут активно размножаться. Часто бывает заразна еда животного происхождения. Поэтому нельзя есть продукты, которые продавались на рынке в не прикрытом виде, например, колбасные изделия без упаковки.
Основные проявления болезни
Признаки кишечной палочки у взрослых и детей могут различаться в зависимости от разновидности бактерии. Но выделяют и ряд общих симптомов:
- Нарушения стула. Могут происходить запоры или диареи.
- Болевые ощущения в области брюшной полости.
- Зловонный запах изо рта.
- Тошнота и рвотные позывы.
- Каловые массы приобретают нехарактерный запах.
- Человек быстро устает и постоянно чувствует себя сонным.
- Наблюдается резкое снижение аппетита.
- Вздутие живота.
То, как выглядит клиническая картина болезни, зависит от вида бактерий и их локализаций. Исходя из типа кишечной палочки, выделяют симптомы:
- Энтеротоксигенные палочки приводят к некрозу тканей кишечника. Это сопровождается диареей с примесью крови, частыми приступами рвоты, болевыми ощущениями в области живота.
- Энтерогеморрагические бактерии приводят к появлению ярких симптомов интоксикации организма, стул становится водянистым, в нем обнаруживается примесь крови.
- Симптомами энтеропатогенной кишечной палочки становится потеря аппетита, рвотные позывы, дети часто срыгивают, проблемы с засыпанием.
- Энтероинвазивная инфекция проявляется водянистым стулом с примесями крови, болевыми ощущения в нижней части живота, приступами тошноты.
- Гемолизирующая инфекция проявляется примесями крови в кале, кровоизлияниями, которые заметны на кожных покровах, появлением желтухи, снижением уровня гемоглобина.
Первые симптомы заражения кишечной палочкой появляются спустя несколько дней после инфицирования. Если вовремя не принять соответствующие меры, развиваются патологии внутренних органов.
Определение точного диагноза
В домашних условиях достоверно определить наличие и конкретный вид кишечной палочки невозможно. Для постановки точного диагноза потребуются лабораторные исследования. Существует несколько методик:
- Бактериоскопическая. У пациента берутся образцы содержимого кишечника, вагинальный мазок, анализ мочи и крови. Все отобранные материалы изучаются под микроскопом.
- Бактериологическая. Отобранный у пациента биологический материал переносится в специальную благоприятную среду. Если кишечная палочка присутствует, то спустя некоторое время она начинает активно размножаться. В некоторых случаях впоследствии может проводиться антибиотикограмма. С ее помощью определяется чувствительность бактерии к различным видам актибактериальных препаратов.
- Если инфекция локализована в кишечнике, то необходимо исследование на определение степени дисбактериоза.
Только после того, как патогенная кишечная палочка обнаружена и определен ее вид, специалист может ставить точный диагноз и разрабатывать методику, как бороться с проблемой.
Особенности лечения
Подход к тому, как лечить кишечную палочку, должен быть комплексным. Терапия должна проводиться под обязательным контролем специалиста. Выделяют следующие особенности правильного лечения:
- Применение антибактериальных препаратов. Для того чтобы терапия прошла максимально успешно, в лабораторных условиях определяют, какие антибиотики убивают кишечную палочку в конкретном случае. С этой целью проводится специализированное исследование. Избавиться от кишечной палочки можно после окончания двухнедельного курса медикаментозного лечения. Спустя два месяца после окончания терапии необходимо провести повторный бактериологический посев для контроля. Если повторно выявляется инфицирование, то курс приема антибиотиков придется повторить. Только так можно будет окончательно убить кишечную палочку. Сколько лечится заболевание, будет зависеть от особенностей организма пациента и степени заражения.
- Терапия осложнений. Если заражение спровоцировало развитие сопутствующих заболеваний, то в программу лечения входят мероприятия по их устранению. Для этих целей применяются соответствующие лекарственные препараты.
- Соблюдение диетического рациона. Вылечить кишечную палочку можно при соблюдении особого режима питания. В меню должно входить больше каш, приготовленных на воде, слизистых супов, отварных овощей, нежирного мяса и рыбы, приготовленных на пару. Категорически запрещено питаться копченостями, жирными и жареными блюдами, консервами, молоком, свежими фруктами, пряностями.
- Когда кишечная инфекция сопровождается сильной рвотой и диареей, происходит обезвоживание организма. Для того чтобы восстановить нормальный баланс, пациенту необходимо пить как можно больше чистой воды. В тяжелых случаях применяются лекарственные препараты, например, регидрон или трисоль. Помимо этого, рекомендуется применять сорбенты с первых же дней болезни. Хороший результат дает лечение энтеросгелем, смектой, полисорбом и другими препаратами этой группы.
- Допускается и лечение народными средствами. Применение рецептов нетрадиционной медицины возможно только совместно с консервативной терапией. Хорошо помогает средство, изготовленное на основе топинамбура. Около 250 грамм очищенных клубней необходимо нашинковать небольшими ломтиками и переложить в ковш. Туда же влить стакан молока и такое же количество воды. Варить топинамбур необходимо до тех пор, пока он не станет полностью мягким. Полученный отвар отфильтровывают. В приготовленную жидкость добавляют немного сливочного масла и муки. Немного уваривают. Таким соусом заливают оставшийся топинамбур и сдабривают свежей зеленью. Такое блюдо можно есть на завтрак или обед. Оно эффективно борется с бактериями и восстанавливает микрофлору кишечника.
Любые народные средства имеют противопоказания. Перед их применением необходимо непременно проконсультироваться с врачом.
Теперь вы знаете, чем лечат кишечную инфекцию. Конкретные препараты и их дозировки подбираются специалистом индивидуально для каждого пациента.
Профилактические действия
Для того чтобы предотвратить заражение кишечной палочкой, необходимо соблюдать простые меры предосторожности. Профилактика включает в себя:
- Соблюдение всех принципов личной гигиены. Старайтесь как можно чаще мыть руки, особенно после пребывания в общественных местах.
- Взрослым, ведущим активную половую жизнь, необходимо помнить о правилах интимной гигиены.
- Не ешьте немытые фрукты и овощи.
- При приготовлении блюд следите за тем, чтобы продукты хорошо проваривались. Не режьте мясо и остальные продукты на одной и той же разделочной доске.
- Все оставшиеся блюда обязательно храните в холодильнике.
- Не пейте воду из водопровода и неизвестных источников. Безбоязненно можно пить только кипяченую воду.
Соблюдая простые правила, можно обезопасить себя от кишечной палочки. Но если заражение все же произошло, нужно как можно быстрее принимать меры.
otravlenye.ru
Как передается кишечная палочка 🚩 кишечная палочка передается 🚩 Заболевания
Микроорганизм под названием «кишечная палочка», входящий в состав микрофлоры желудочно-кишечного тракта человека, получил свое название из-за характерной продолговатой формы. Кишечная палочка при обычных условиях относится к условно-патогенным микроорганизмам, то есть она не вредит здоровью. Но иногда такие бактерии могут навредить организму.Такое инфекционное заболевание как дизентерия, носит неофициальное название «болезнь грязных рук». Точно так же происходит и заболевание эшерихиозом – инфекционной болезнью, вызванной кишечной палочкой. Болезнь названа так, потому что латинское обозначение кишечной палочки – «эшерихиа коли».
Механизм заражения – попадание бактерий кишечной палочки в ротовую полость при несоблюдении гигиены рук после посещения туалета, контакта с зараженными животными, работы на ферме или собственном подворье и т.д. Болезнь может протекать как в относительно слабой форме, так и в очень тяжелой, по симптомам напоминающей холеру. Чтобы избежать заболевания эшерихиозом, необходимо тщательно мыть руки с мылом.
Кишечные палочки могут попасть в рот при употреблении питьевой воды из загрязненных источников, при купании в общественном плавательном бассейне (если он не обеззараживается хлором или иными реагентами), а также в природных водоемах, куда попадают сточные воды, пусть даже в очень малом количестве.
Также источниками заболевания могут послужить мясные блюда, не прошедшие достаточную термообработку, не пастеризованное молоко и соки. Можно заразиться, если использовать для охлаждения напитков лед, приготовленный из недостаточно чистой воды.
Чаще всего инфекция передается контактно-бытовым путем (через общие предметы обихода, посуду, постельное белье). Поэтому, согласно медицинской статистике, больше всего заболеваний происходит в яслях, детских садах – до 30% случаев. Заболеваний среди детей, не посещающих общественные дошкольные учреждения, а также среди взрослых, случаются гораздо реже.
Наиболее тяжело болезнь протекает у ослабленных детей – недоношенных или перенесших серьезные заболевания, из-за чего заметно снижается иммунитет. При первых признаках кишечной инфекции следует вызвать врача. Возможно, малыша госпитализируют. В некоторых случаях назначают амбулаторное лечение.
Кишечная палочка – это вполне нормальное явление для человеческого организма. Она играет важную роль в процессе переваривания пищи, находится во флоре кишечника и является одним из главных компонентов нормальной работы органов пищеварения.

Инструкция
Однако имейте ввиду, что в результате ослабления иммунитета кишечная палочка может начать размножаться быстрыми темпами и стать возбудителем огромного числа болезней, особенно у женщин, что связано с особенностями строения половой системы. При проникновении кишечной палочки в уретру или влагалище может возникнуть острый цистит, уретрит или вульвовагинит. Помните, что пищевая инфекция, вызванная кишечной палочкой, самая распространенная. В почве, листьях растений, грязной воде она находится в избытке. Поэтому обязательно соблюдайте меры профилактики, мойте руки перед каждым приемом пищи, не употребляйте не мытую зелень, фрукты и овощи, пейте только кипяченую воду.Если в вашем организме обнаружили патогенную кишечную палочку, принимайте антибиотики. Для кишечной палочки характерно быстрое взаимодействие с другими возбудителями заболеваний, что может вызвать тяжелое течение болезни, требующее длительного и сложного лечения. У детей кишечная палочка может быть обнаружена даже в легких. В некоторых случаях происходит неконтролируемое ее распространение по всему организму.
Однако помните, что принимать антибиотики самостоятельно нельзя. Неконтролируемый прием может привести к нарушению микрофлоры кишечника, т.е. дисбактериозу, что является причиной еще большего ослабления иммунитета. Чтобы избежать неприятностей, обязательно сдайте анализы, чтобы провести посев на чувствительность ко всем видам антибиотиков, поскольку многие бактерии устойчивы к ним.
Кроме того, вам могут назначить бактериофаги. Но они, как и антибиотики, убивают не только патогенную кишечную палочку, но и представителей полезной микрофлоры. Чтобы такого не произошло, принимайте пробиотики. Они позволяют быстро и эффективно восстановить количество полезных микроорганизмов, препятствуя развитию дисбактериоза.
В качестве средства народной медицины используйте мумие. Принимайте по пол грамма утром, в обед и вечером перед приемом пищи в течение 3-х недель. После этого сделайте 5-дневный перерыв, а затем повторите лечение, если такая необходимость возникнет.
Источники:
- как вылечить кишечную палочку
В жаркую летнюю пору резко возрастает количество людей, заразившихся кишечными бактериями. При соблюдении определенных рекомендаций вы сможете обезопасить свой организм от опасных микроорганизмов.

Инструкция
Несомненно, летом продукты портятся быстро, поэтому в данное время года есть большая вероятность съесть что-либо недоброкачественное. Бактерии бурно размножаются в жару, попав в мясные, молочные и даже кондитерские изделия. Кроме этого, возникает острая потребность в воде, но не всегда (на природе) есть возможность раздобыть безопасную и чистую воду, да и создать условия для ее кипячения не всегда можно. Также неоспоримый факт, что кишечная палочка является болезнью грязных рук. Чтобы обезопасить себя и своих близких от воздействия кишечной палочки, соблюдайте следующие правила: откажитесь от покупки импортных овощей и фруктов. Чтобы полностью удостовериться, что вас не обманывают, потребуйте сертификат качества, где будет указана родина привезенных фруктов. Старайтесь употреблять в пищу овощи, выращенные собственными руками на огороде, только так вы сможете быть полностью уверены в том, что они не содержат вредных веществ. При этом не поливайте грядки настоем из коровьего навоза, собранного на лугу. Это может быть опасным для вашего здоровья.Приобретенные или собранные овощи и фрукты необходимо тщательно мыть под проточной водой. Желательно для этих целей использовать хозяйственное мыло. Салат, петрушку или другую зелень перед употреблением замочите на пару часов в холодной воде.
Ни в коем случае перед покупкой не пробуйте на рынке ягоды, фрукты или овощи. Откажитесь от приобретения разрезанных арбузов или дынь, не просите надрезать их на улице. Всегда (вернувшись с улицы, после посещения туалета, перед приемом пищи) тщательно мойте руки с мылом. Уделяйте особое внимание области между пальцами и стригите коротко ногти. Пейте только бутилированную (промышленного производства) или кипяченую питьевую воду. Не используйте воду из водоемов даже в технических целях.
Тщательно прожаривайте или проваривайте мясо и фарш. Для резки овощей и разделки мяса пользуйтесь отдельными досками и ножами. После употребления тщательно мойте кухонную утварь с помощью горячей воды и хозяйственного мыла. Избавьтесь от привычки грызть ногти и ручку. Принесенные ребенком игрушки из детского сада или с улицы следует тщательно мыть с мылом.
www.kakprosto.ru